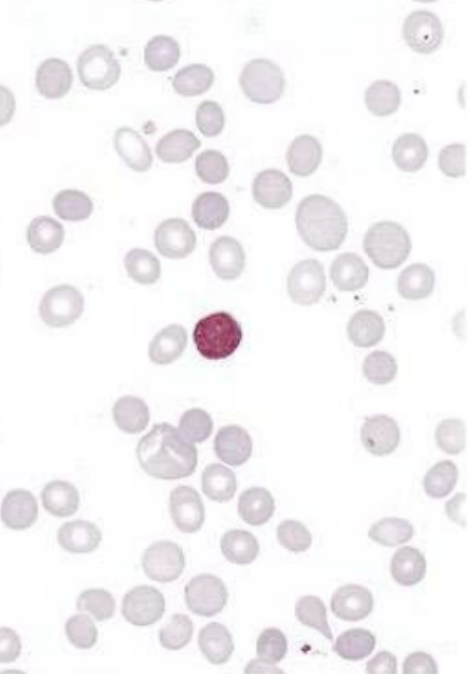

Let's make this go viral for everyone studying for the USMLE. - The Top 10 Dreaded Highest Yield Images - (I'll give clinical scenario, image & management of some of the most high yield/tricky images you'll see on test day!)
UPPER lobe infiltrate + hemoptysis/weight loss = reactivation TB Key in history: AFTER a patient was treated w/ infliximab (or other TNF-a inhibitors: etanercept, adalimumab, certolizumab bc it blocks granuloma structure) **This is ALMOST always in a patient tx for rheum dz
Large aortic thrombus + eosinophilia + blue toes/livedo reticularis = Cholesterol emboli **Key is eosinophilia. TQ may give you DECREASED complement levels too Tx: anti-platelet (ASA) - Essentially pieces of cholesterol are flicking down to small arteries/capillaries
Pain caused by hip flexion/extension + ring enhancing mass in pic: - Psoas abscess! MCC = S. aureus (TB or Salmonella if from discitis) Tx: Abx + Percutaneous drainage or open surgical drainage (if from perforated bowel) if > 7cm HPI usually includes IVDU/DM/Immunosuppressed
CLL + elevated indirect bilirubin + anemia: - Warm Autoimmune hemolytic anemia (WAHA) ** WAHA also assoc w/ SLE and PCN or a-Methyldopa (via HAPTENATION = shoutout to Goljan!!!) Tx: (stop offending med) --> Steroids --> IVIG --> Splenectomy --> Rituximab/Azathioprine
Recurrent epistaxis + AVM + telangiectasia: - Osler-Weber-Rendu Syndrome (aka Hereditary Hemorrhagic Telangiectasia) HY Assoc: Can result in cerebral AVM --> hemorrhagic strokes or - Cerebral abscesses due to venous blood bypassing Pulm circulation if there's a pulmonary AVM!
Tinea versicolor due to Malassezia furfur Tx? - zinc pyrithione 1% shampoo - selenium sulfide 2.5% shampoo - ketoconazole shampoo - sulfur salicylic acid shampoo - Azole creams ^ You'll notice the answer options for 1st line = TOPICAL ONLY use oral -azoles if refractory
Itchy, well demarcated CD4+ red plaques (erythroderma): - Mycosis Fungoides (if TQ tells you Sezary cells in peripheral smear +/- "hepatosplenomegaly/LAN" = Sezary Syndrome) Dx: Biopsy w/ lymphocytic infiltrate + microabscesses (Pautrier's Abscesses) within thickened epidermis
IV drug abuse + S. aureus/Candida bacteremia + new onset systolic murmur along the left sternal border: - tricuspid regurgitation from Infective endocarditis (Arrow C on image below) Dx: Echo Tx: IV Abx. Surgery only if ABSCESS, or refractory to abx or HF due to endocarditis
Infective Endocarditis causes: - If SLE = Libmann Sacks Endocarditis (mitral or aortic) - If colon cancer = Strep gallolyticus (formerly S. bovis) - If Culture Negative = HACEK / Coxiella / Bartonella - If prosthetic valve = S. epidermidis
Infective Endocarditis causes Part 2: - If pancreatic cancer = Marantic endocarditis (nonbacterial thrombotic) - If dental procedure = Strep viridans - If GI/GU infection = Enterococcus **Use context clues & tailor IV Abx based upon cause!
Supratentorial tumor (Rathke's pouch in children) + dystrophic calcification + bitemporal hemianopsia: - Craniopharyngioma! Be careful! Most people assume this is pituitary adenoma due to location & visual defect. The pituitary gland is often COMPRESSED here. Tx: Surgery
Stab wound to abdomen (also seen w/ perforated diverticulitis or ischemic bowel) + air under diaphragm: Physical Exam: peritoneal signs = guarding/rigidity/rebound tenderness If elevated lactate = due to anaerobic respiration (ischemic bowel) Tx: IV abx + Ex Lap to repair perf
I hope you enjoyed this! These *may* have shown up on Step 1 & Step 2 ;) Like, Bookmark for later & please Retweet to spread the high yields. Lmk if you'd like me to make a Part 2 Highest Yield images guide!
If this gets enough traction I’ll record a video walkthrough guide for the highest yield images too🔥
Part 2 Review Guide Below ⬇️
If you're a med student and would like to book a free call to discuss study strategy/classes/USMLE/COMLEX/rotations: https://www.actionpotentialmen...
Note: all concepts here are purely conceptual and not representative of actual USMLE / COMLEX questions.